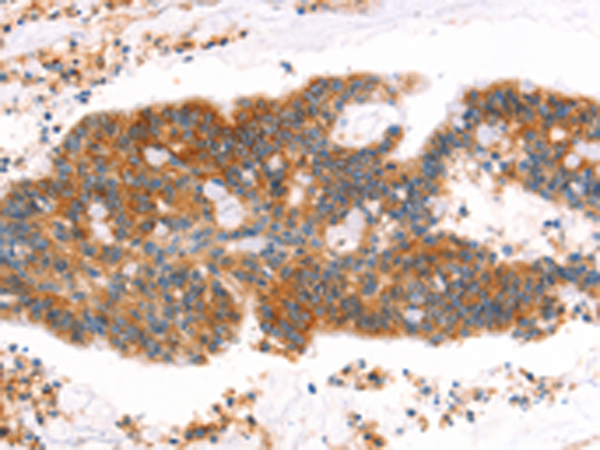
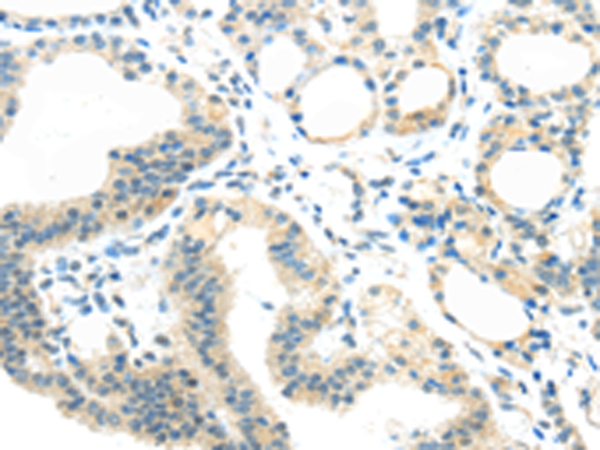

-
分类: 科研抗体货号: P11215别名: ARTS; DFN2; PRSI; CMTX5; DFNX1; PRS-I; PPRibP/PRSII/PRPS1; PRPS3; PRPSL; PRS-III应用: WB,IHC反应种属: Human, Mouse
-
分类: 科研抗体货号: P11235别名: G3; BAT3; BAG-6; D6S52E应用: WB反应种属: Human, Mouse, Rat
-
分类: 科研抗体货号: P11255别名: CEA; CGM1; W264; W282; CD66D应用: WB,IHC反应种属: Human, Mouse
-
分类: 科研抗体货号: P11234别名: P38; JTV1; JTV-1; PRO0992应用: WB,IHC反应种属: Human, Mouse, Rat
-
分类: 科研抗体货号: P11275别名:应用: IHC反应种属: Human, Mouse, Rat
-
分类: 科研抗体货号: P11254别名: BGP; BGP1; BGPI应用: WB,IHC反应种属: Human
-
分类: 科研抗体货号: P11233别名: AF6; MLLT4; MLL-AF6; l-afadin应用: IHC反应种属: Human, Mouse, Rat
-
分类: 科研抗体货号: P11273别名: GC4, RTP, DRG1, NDR1, NMSL, TDD5, CAP43, CMT4D, DRG-1, HMSNL, RIT42, TARG1, PROXY1应用: WB,IHC反应种属: Human, Mouse, Rat
-
分类: 科研抗体货号: P11253别名: MLA1; ME491; LAMP-3; OMA81H; TSPAN30应用: WB,IHC反应种属: Human, Mouse
-
分类: 科研抗体货号: P11232别名: ACLP应用: IHC反应种属: Human, Mouse, Rat

鄂公网安备42018502007531号
鄂公网安备42018502007531号

